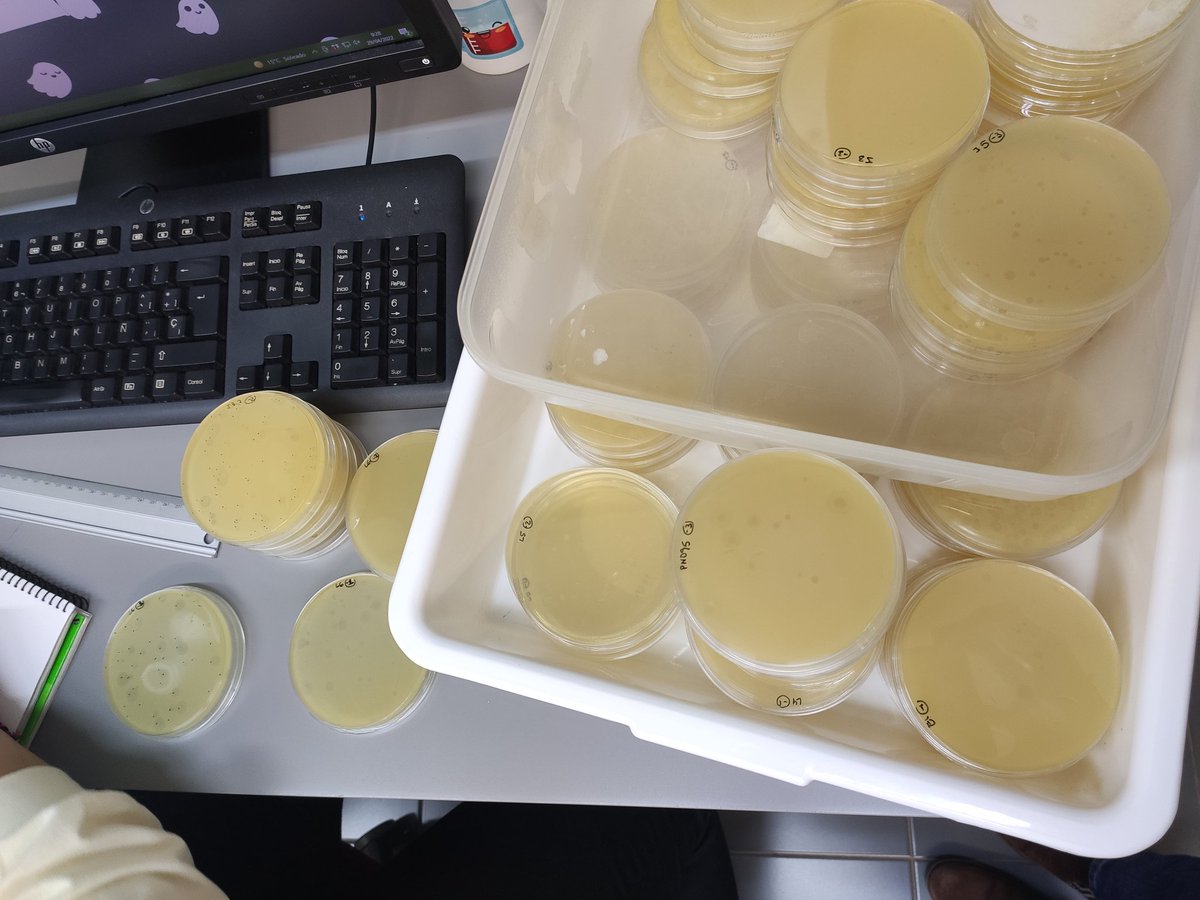
VISAFELab tweet media

Inés Girón Guzmán retweetledi

Gracias por la oportunidad de presentar las líneas de investigación del grupo y los casos de éxito en transferencia
Food for Life-Spain@Food4LifeSPAIN
🗣️ @iata_csic ➡️ Aproximaciones desarrolladas en el IATA para el control de diversos tipos de riesgos en alimentos. 🗣️ @Cleanity_es ➡️ Cómo impacta la digitalizacvión y biotecnología en la seguridad alimentaria.
Español